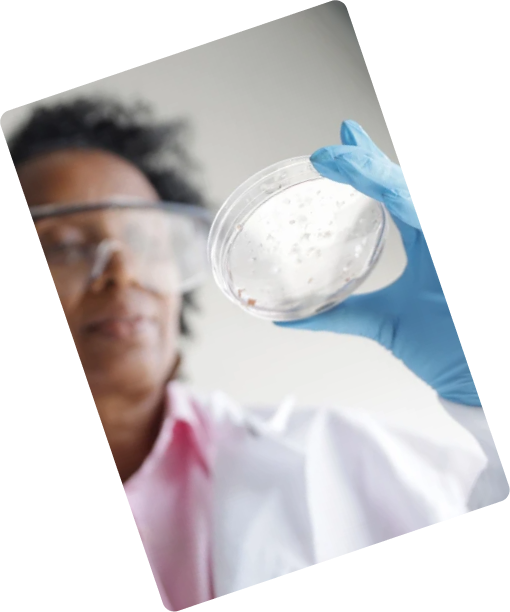

pharmaceutical companies around the globe capturing both
national & international markets.
QUICK LINKS
GLOBAL PRESENCE
- Read More
- AFRICA
- ASIA
- MIDDLE EAST


About Us
We’re transforming healthcare
Since its inception in 2018, Pharmaqio has been sailing ahead to establish itself as one of the most rapidly growing pharmaceutical companies — capturing both national and international markets.
Our focus is on research-based, high-quality medicines that meet global standards of safety and efficacy. With a strong vision and a skilled team, Pharmaqio continues to expand its footprint across the healthcare industry.
Our Products














Vision
The company has not confined itself to the boundaries of Pakistan but intends to target the international market as well, and has already started export to many countries.
Mission
Companys mission is to serve the healthcare industry with pharmaceutical products that are bioequivalent to the research brands at affordable prices.
At Pharmaqio , we deliver trusted, quality medicines to patients across the globe—with integrity at the core of everything we do.

Driving innovation across therapeutic areas
We develop and market safe, effective, and high-quality medicines spanning a broad range of therapeutic segments.
What we offer
Live happily, Live healthily
Generic Medicine
Dignissim libero donec accumsan cubilia consectetuer lobortis ornare si vehicula amet fames
Health Checks & Screening
Dignissim libero donec accumsan cubilia consectetuer lobortis ornare si vehicula amet fames
Vaccination
Dignissim libero donec accumsan cubilia consectetuer lobortis ornare si vehicula amet fames
Medicine Consultation
Dignissim libero donec accumsan cubilia consectetuer lobortis ornare si vehicula amet fames
Doctor Receipt
Dignissim libero donec accumsan cubilia consectetuer lobortis ornare si vehicula amet fames
Pharmacy Store
Dignissim libero donec accumsan cubilia consectetuer lobortis ornare si vehicula amet fames
Our Products
Pharmaqio offers a diverse portfolio of products designed to treat a wide range of medical conditions.






Our promises
Why you should choose us.
Lorem ipsum dolor sit amet, consectetur adipiscing elit.
Honesty & transparency
Dignissim libero donec accumsan cubilia consectetuer lobortis ornare si vehicula amet fames
Extra Discount
Dignissim libero donec accumsan cubilia consectetuer lobortis ornare si vehicula amet fames
24/7 Support
Dignissim libero donec accumsan cubilia consectetuer lobortis ornare si vehicula amet fames
Get in Touch With Us
We’re here to answer your questions or provide more information about our products and services. Fill out the form below, and our team will get back to you shortly.
Ready to become our member?
Let’s Connect
Whether you’re looking to collaborate, distribute our products, or learn more about Pharmaqio’s growing portfolio, we’re always open to meaningful conversations. Our team is ready to assist you with any inquiries and provide the information you need.



